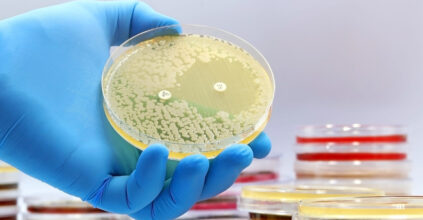

Delivering the answers that advance science, healthcare, and patient outcomes.
Our Services

Clinical Chemistry
Drug & Toxicology Screening, Wellness & Preventive Health Panels, and more
“Fast, affordable, technology-driven diagnostics designed to lower costs and elevate patient care.”
— Core Values
Healthy Lifestyle
Great results start with great habits. Drink water, fast when needed, avoid hard workouts, and get good rest before your test. Your lifestyle choices today shape your health tomorrow.

Driving innovation with AI-Powered Clinical Lab Diagnostics
Clinitch Diagnostics is transforming the future of laboratory testing by combining advanced automation with AI-driven accuracy. Our innovative first approach ensures every test is processed with clinical excellence, modern technology, and uncompromising quality.
FAQs
Questions Welcome
What are your laboratory operating hours?
We are open for testing and sample collection from 9:00 am-6 pm. Scheduled appointments, onsite & mobile testing are welcome.
Do I need an appointment for testing?
Yes. Clinitch Diagnostics accept. However, booking ahead can reduce wait time and ensure faster service.
Do you accept insurance?
Clinitch Diagnostics works with multiple insurance providers. In addition, we offer affordable self-pay options and transparent pricing for all tests. Please get in touch with us to confirm coverage or verify your benefits.
Do you offer mobile or home sample collection?
Yes. We provide on-site and mobile phlebotomy services for individuals, businesses, and healthcare providers. Just so you know, appointments are required.
Blogs

Essential Health Tests Every Adult Should Take, And Why Early Screening Saves Lives
Staying healthy is more than visiting the doctor once a year , it starts with regular laboratory testing that helps detect health issues early, even before symptoms show.

How Regular Health Screening Can Add 10 More Years to Your Life
Research shows that people who undergo annual health screenings reduce their risk of serious diseases by up to 70%.